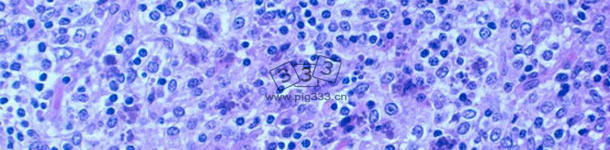
严重的淋巴细胞减少伴有淋巴组织肉芽图

我们应该担心PCV-3吗?
我们正在寻找更多的证据证明PCV-3可能在某些生殖问题中发挥作用。
我们与众不同之处在于网站内容的优质与信息的独立性。众多业内知名专家学者为网站积极撰稿,保证了网站内容的品质。
Joaquim Segalés1968年出生在西班牙的巴塞罗那,1991年毕业于巴塞罗那自治大学(UAB)的兽医学院。他在美国明尼苏达大学的马里亚诺·多明戈博士(UAB)和卡洛斯博士(UM)的指导下进修了15个月后,又于1996年获得了UAB的博士学位。2000年,Joaquim Segalés取得了欧洲学院兽医病理学(ECVP)的文凭。2004年,他从欧洲猪健康与管理学院(ECPHM)毕业,同时也是这所大学的创建者之一兼现任副总裁。目前,他担任UAB的兽医学院动物解剖与福利部门教授,同时也是CReSA 的主管。
Joaquim博士参与了多个国家级和欧洲级的研究项目。他尤其擅长各种猪疾研究并与全球多个企业合作。他参加的多项研究中,最重要的有猪繁殖与呼吸综合征病毒(PRRSV)、副猪嗜血杆菌、伪狂犬病病病毒(ADV)、戊型肝炎病毒(HEV)、猪细环病毒及猪圆环病毒2型(PCV2)。
值得一提的是,Joaquim博士于1997年参与了西班牙首个断奶仔猪多系统衰竭综合症或猪圆环病的确诊,以及1996年猪皮炎和肾病综合症的确诊工作。凭借这些调查结果,他在国际科学期刊上发表了200余篇文章,并为国际知名的书籍合著了十章内容。他同时也是有关猪尸检的书籍以及有关猪临床病例的三本书的作者之一。
更新的简历 14-5月-2013

猪圆环病毒2型(PCV2)已经成为对生猪生产破坏性最大的病毒,造成相当大的经济影响(直接损失和控制疾病的花费)。PCV2是断奶仔猪多系统衰竭综合征(PMWS)的病原体,目前被称为PCV2-系统性疾病(PCV2-SD, 图 1)。流行病学和和实验研究已证明基因多样性可能影响PVC2的毒力,表现为在全球范围内出现新的基因型以及重组株的流行。也许这正是为什么PCV2种间分类颇具争议的原因。2008年,欧盟猪圆环病毒病联盟提出了以成对基因序列比较为基础的PCV2基因型标准命名法(www.pcvd.eu)。通过分析PCV2完整和衣壳(ORF2)核苷酸序列确定了2个距离阈值,分别为0.020 和0.035。当2个序列之间的遗传距离大于这两个阈值时,认为这些毒株属于不同的基因型。分析发现了4种基因型,分别命名为PCV2a, PCV2b, PCV2c和 PCV2d(也被称为PCV2b突变型)。

21周时,血清PCV2含量“高”和“中”的猪与血清病毒含量“负数/低”猪相比,每头猪平均损失13.1欧元 和7.5 欧元。

毫无疑问,免疫PCV2疫苗后可以改善亚临床感染仔猪的生产性能,从而提高经济效益。母猪在整个过程中发挥什么作用?疫苗是否对亚临床感染的母猪产生积极影响?

目前所有市售疫苗要面对的一个问题是要排除母源免疫的干扰;另一个问题是大部分市售疫苗在接种后是否能够在母源抗体存在的情况下独自产生抗体滴度。

_51518.jpg?w=650&h=366&ho=1&t=1653979446)
和患病毒血症仔猪的平均病毒数(柱体)对比值。两项指标都是通过对3周龄仔猪接种疫苗和未接种疫苗的猪群实施定量聚合酶链反应测得的。_51521.jpg?w=650&h=366&ho=1&t=1653979446)



